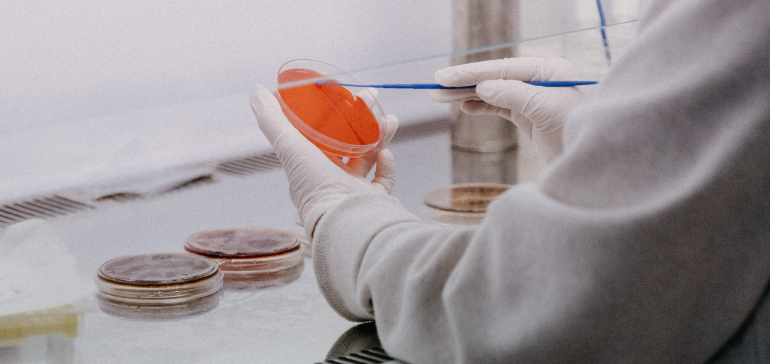

Das LIMCR
Das LIMCR (Labor für Immunologische und Molekulare Krebsforschung) verbindet, seit der Gründung von Prof. Richard Greil im Jahr 2005, Spitzenforschung mit klinischer Praxis. Im Fokus der Forschung stehen Leukämieerkrankungen, insbesondere die Chronische Lymphatische Leukämie (CLL), das Myelodysplastische Syndrom (MDS) und die Akute Myeloische Leukämie (AML). Unser besonderer Ansatz ist die enge Verbindung von Labor und Klinik: Forschung an Tumormaterial und klinische Beobachtungen greifen direkt ineinander. Ziel ist es, wissenschaftliche Erkenntnisse rasch in innovative, individuell zugeschnittene Diagnose- und Therapieansätze zu übertragen – für eine moderne Krebsmedizin mit direktem Nutzen für Patientinnen und Patienten.
Mit translationaler Krebsforschung auf international wettbewerbsfähigem Niveau arbeiten wir daran, bestehende Therapien zu verbessern und innovative, individuell zugeschnittene Behandlungsstrategien für Patientinnen und Patienten zu entwickeln.
Forschungsprojekte
News
Sie haben ein Anliegen oder Fragen?
Nehmen Sie mit uns Kontakt auf – wir melden uns umgehend bei Ihnen zurück.